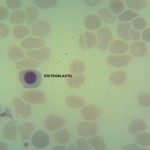
Foto da extensão sanguínea 2
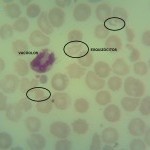
Foto da extensão sanguínea 3
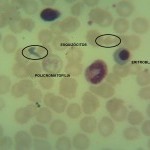
Foto da extensão sanguínea 4
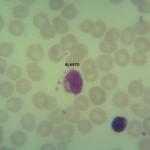
Foto da extensão sanguínea 5
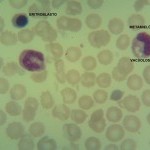
Foto da extensão sanguínea 6

Caso nº 10
Caso Clínico #12
Local: Curitiba-PR
Mês / Ano: Setembro/2012
Assuntos relacionados: TROMBOCITOPENIA. SEXO MASCULINO
Quadro Clínico
Paciente do sexo masculino, 36 anos.
Com base nos dados clínicos e laboratoriais, propomos as seguintes questões para discussão do caso:
Com base no resultado do hemograma e nas fotos da extensão sanguínea indique a hipótese diagnóstica laboratorial e faça uma breve discussão sobre sua escolha.
Referências Bibliográficas
SILVA, Paulo Henrique, et al. Hematologia Laboratorial: teoria e procedimentos. Porto Alegre, Ed. Artmed, 2016.
Dados Laboratoriais
-
Eritrócitos
3.380.000/uL
Hemoglobina
12,0 g/dL
Volume globular
37,0%
VCM
109,5 fL
HCM
35,5%
CHCM
32,4%
Leucócitos
13.200/uL
Plaquetas
102.000/uL
Linfócitos
32%
Monócitos
02%
Blastos
01%
Mielócitos
04%
Metamielócitos
04%
Bastonetes
33%
Segmentados
24%
Neutrófilos
57%
Eritroblastos
47%
Anisocitose ++
Policromatofilia ++
Esquizócitos ++
Granulações tóxicas +
Vacúolos +
Respostas da discussão
Hipótese diagnóstica laboratorial
Processo infeccioso bacteriano agudo com consequente púrpura trombocitopênica trombótica.
Discussão do caso laboratorial
Em um primeiro momento, o que chama a atenção no resultado do hemograma é a grande quantidade de eritroblastos (47). Atualmente, alguns analisadores hematológicos conseguem fazer a distinção entre células brancas nucleadas e células vermelhas nucleadas. O analisador utilizado para a confecção deste hemograma não o faz, então, deve-se corrigir o número de leucócitos. A contagem corrigida de leucócitos foi de 8.979 leucócitos/microlitro. A contagem diferencial mostra a presença de granulócitos imaturos, de granulações tóxicas e de vacúolos. A associação de granulócitos imaturos com granulações tóxicas e vacúolos caracteriza um hemograma infeccioso. Foi encontrado, inclusive, um blasto, o que não é comum em processos infecciosos. Este hemograma é característico de um processo infeccioso bacteriano agudo. Como o número de leucócitos está dentro valor de referência (8.979), pode-se dizer que o quadro infeccioso é compatível com uma produção (medula óssea) igual que o consumo (tecido).
Foi caracterizado, até o momento, o quadro de um processo infeccioso bacteriano agudo. A série vermelha mostra a presença de policromatofilia (++). A associação da policromatofilia com os eritroblastos, que estão no sangue periférico em um número bastante significativo, sugere um quadro hemolítico. Também chama a tenção a presença de esquizócitos (++). O esquizócito quando associado a policromatofilia e aos eritroblastos também sugere um quadro hemolíco. A policromatofilia significa reticulocitose, o reticulócito é um eritrócito jovem com grande conteúdo de RNA e que é maior que o eritrócito maduro (geralmente é 25% maior que o eritrócito maduro), isto explica o aumento do VCM (109,5). O aumento do VCM por reticulocitose chama-se pseudomacrocitose.
Fica caracterizado, até o momento, um processo infeccioso bacteriano agudo com hemólise.
A contagem de plaquetas está abaixo do valor de referência (102.000 plaquetas/microlitro), tem-se um quadro de trombocitopenia.
O hemograma mostra, além do processo infeccioso, um quadro de hemólise associado com trombocitopenia e esquizócitos. A tríade hemólise, trombocitopenia e esquizócitos sugere o diagnóstico laboratorial de púrpura trombocitopênica trombótica (PTT). É provável que a causa da PTT seja o quadro infeccioso.
O fator de von Willebrand (FvW) é produzido, entre outros locais, nas células endoteliais e tem como função fazer a adesão plaquetária. O FvW secretado pelas células endoteliais é de alto peso molecular. Ele não pode permanecer no sangue periférico na forma de alto peso molecular, porque nesta forma ele induz uma agregação plaquetária imediata. Uma enzima chamada de ADAMTS13 transforma o FvW em baixo peso molecular, na forma de baixo peso molecular ele exerce a sua função que é a de fazer a adesão plaquetária. Na vigência de um processo infeccioso bacteriano agudo, como neste caso, a enzima ADAMTS13 é inibida e o FvW de alto peso molecular é expresso no sangue periférico, o que induz a uma agregação plaquetária imediata. Esta agregação plaquetária forma trombos plaquetários com consumo de plaquetas (trombocitopenia por consumo), por mais que a medula óssea seja estimulada a produzir plaquetas a agregação ocorre. Estes trombos plaquetários se depositam, preferencialmente, nos rins, na pele e no cérebro. Os trombos, depositados nos vasos sanguíneos, representam uma obstrução ao fluxo sanguíneo, o que explica a presença dos esquizócitos. Os trombos causam isquemia nos órgãos citados e o curso clínico é fulminante e fatal. A forma adquirida da PTT pode não apresentar uma causa precipitante. Geralmente, ocorre no curso de um processo infeccioso, na gestação e em transplantes de célula tronco e no tratamento com ciclosporina.
Na presença da tríade hemólise, esquizócitos e trombocitopenia deve-se pensar, obrigatoriamente, em PTT. A trombocitopenia, inclusive, pode ser severa, com plaquetas abaixo de 10.000 plaquetas/microlitro.